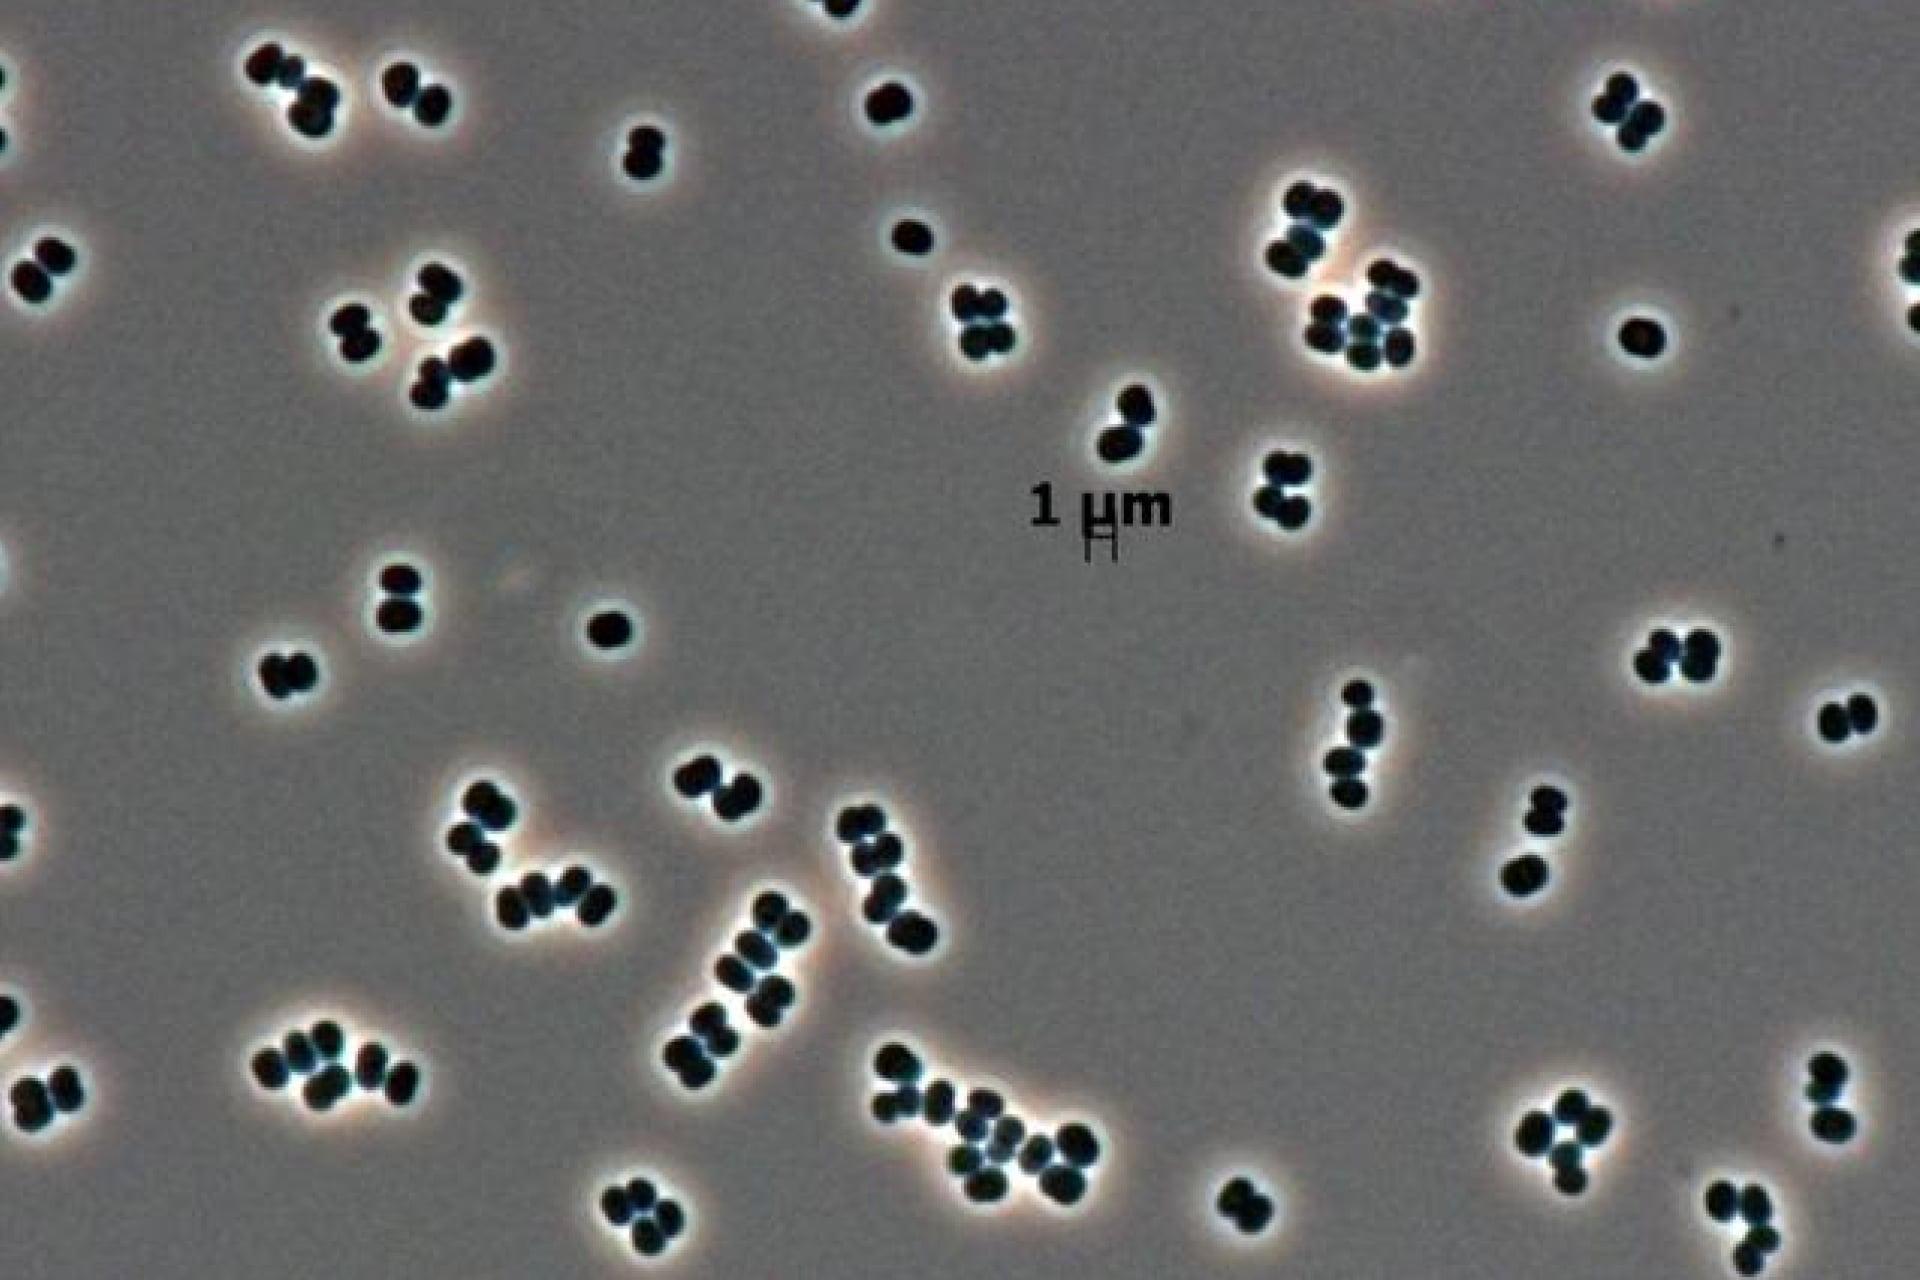
251205thisbacteria.jpg?w=1280&

マイストア
変更
お店で受け取る
(送料無料)
配送する
納期目安:
2026.02.10 5:53頃のお届け予定です。
決済方法が、クレジット、代金引換の場合に限ります。その他の決済方法の場合はこちらをご確認ください。
※土・日・祝日の注文の場合や在庫状況によって、商品のお届けにお時間をいただく場合がございます。
まき散らす菌糸生物 英語版 4枚➕コジレックの命令4枚 匿名配送 wakayama2208zoo1.jpgの詳細情報
wakayama2208zoo1.jpg。横田ボタン店 / REGIA レギア4プライカラー 50g。レギア 4本撚り ウール混紡 段染めソックヤーン – なないろ毛糸。ご覧いただきありがとうございます。複数ご購入の方は、購入前にコメントをお願いします。1枚の価格ですと書いている商品については1枚しかお送りしません。複数枚ほしい場合は事前にコメントをいただければ、価格と枚数を変更いたします。4枚まで(1枚の価格です)と書いている場合4枚くるわけではありません。お間違いないようにご注意下さい。1万円近くの高額商品に関しては、購入者の希望がなくても+210円いただき佐川急便/日本郵便で対応いたします。★注意状態には気を遣っていますが、微細な傷や欠けかある場合がございます。神経質な方はご購入をご遠慮ください。プロフィールを必ずご確認下さい!↑注意点まとめております。お値下げは、相場を見て判断して値段変更いたしますので、コメントをいただいてもお値下げできません。#カーミィのカード屋さん↑こちらご覧ください。★注意郵送事故によるこちらからの返金は致しかねます。ですが、万が一、郵便事故があった場合は、調査依頼を出し、できる限りの対応をさせて頂きます。上記以外の発送方法は出来かねますのでご了承下さい。ご不明点があればコメントよろしくお願いいたします。重量チェック、裏面のお写真、ライトチェックお写真追加可能ですのでご購入前にコメントください。MTG種別...シングルカード。英語語法の征服 改訂版 (マイセレクト) | 綿貫 陽 |本 | 通販 | Amazon。。ニューカペナの街角 日本語セットブースター。統率者マスターズ エルドラージ解放。神河物語 ブースターパック 日本語版 5パック パッケージ全種類 手持ちラスト。【MTG 裏切り者の都】日本語版 マジック・ザ・ギャザリング A。MTG エインシャント・シルヴァー・ドラゴン 英語 1枚。MTG ファイレクシアン・ドレッドノート 日本語 ミラージュ。機械兵団の進軍:決戦の後に コレクター・ブースター エピローグ・ブースター。マジック・ザ・ギャザリング ダスクモーン 統率者デッキ 日本語版 4個。MTG FF ギフトバンドル Gift Bundle。無のロッド 英語 4枚セット。量子の謎かけ屋 4/6 スフィンクス。MTG FF シーンボックス 4種セット 日本語版 未開封。MTG FOIL 英語 ボーダーレス 踏査 Exploration。MTG FINAL FANTASY チョコボ・バンドル 日本語版 1個。瞬唱の魔道士 チョコボバンドル チョコボトラック foil 日本語版
ベストセラーランキングです
近くの売り場の商品
カスタマーレビュー
オススメ度 4.3点
現在、3513件のレビューが投稿されています。